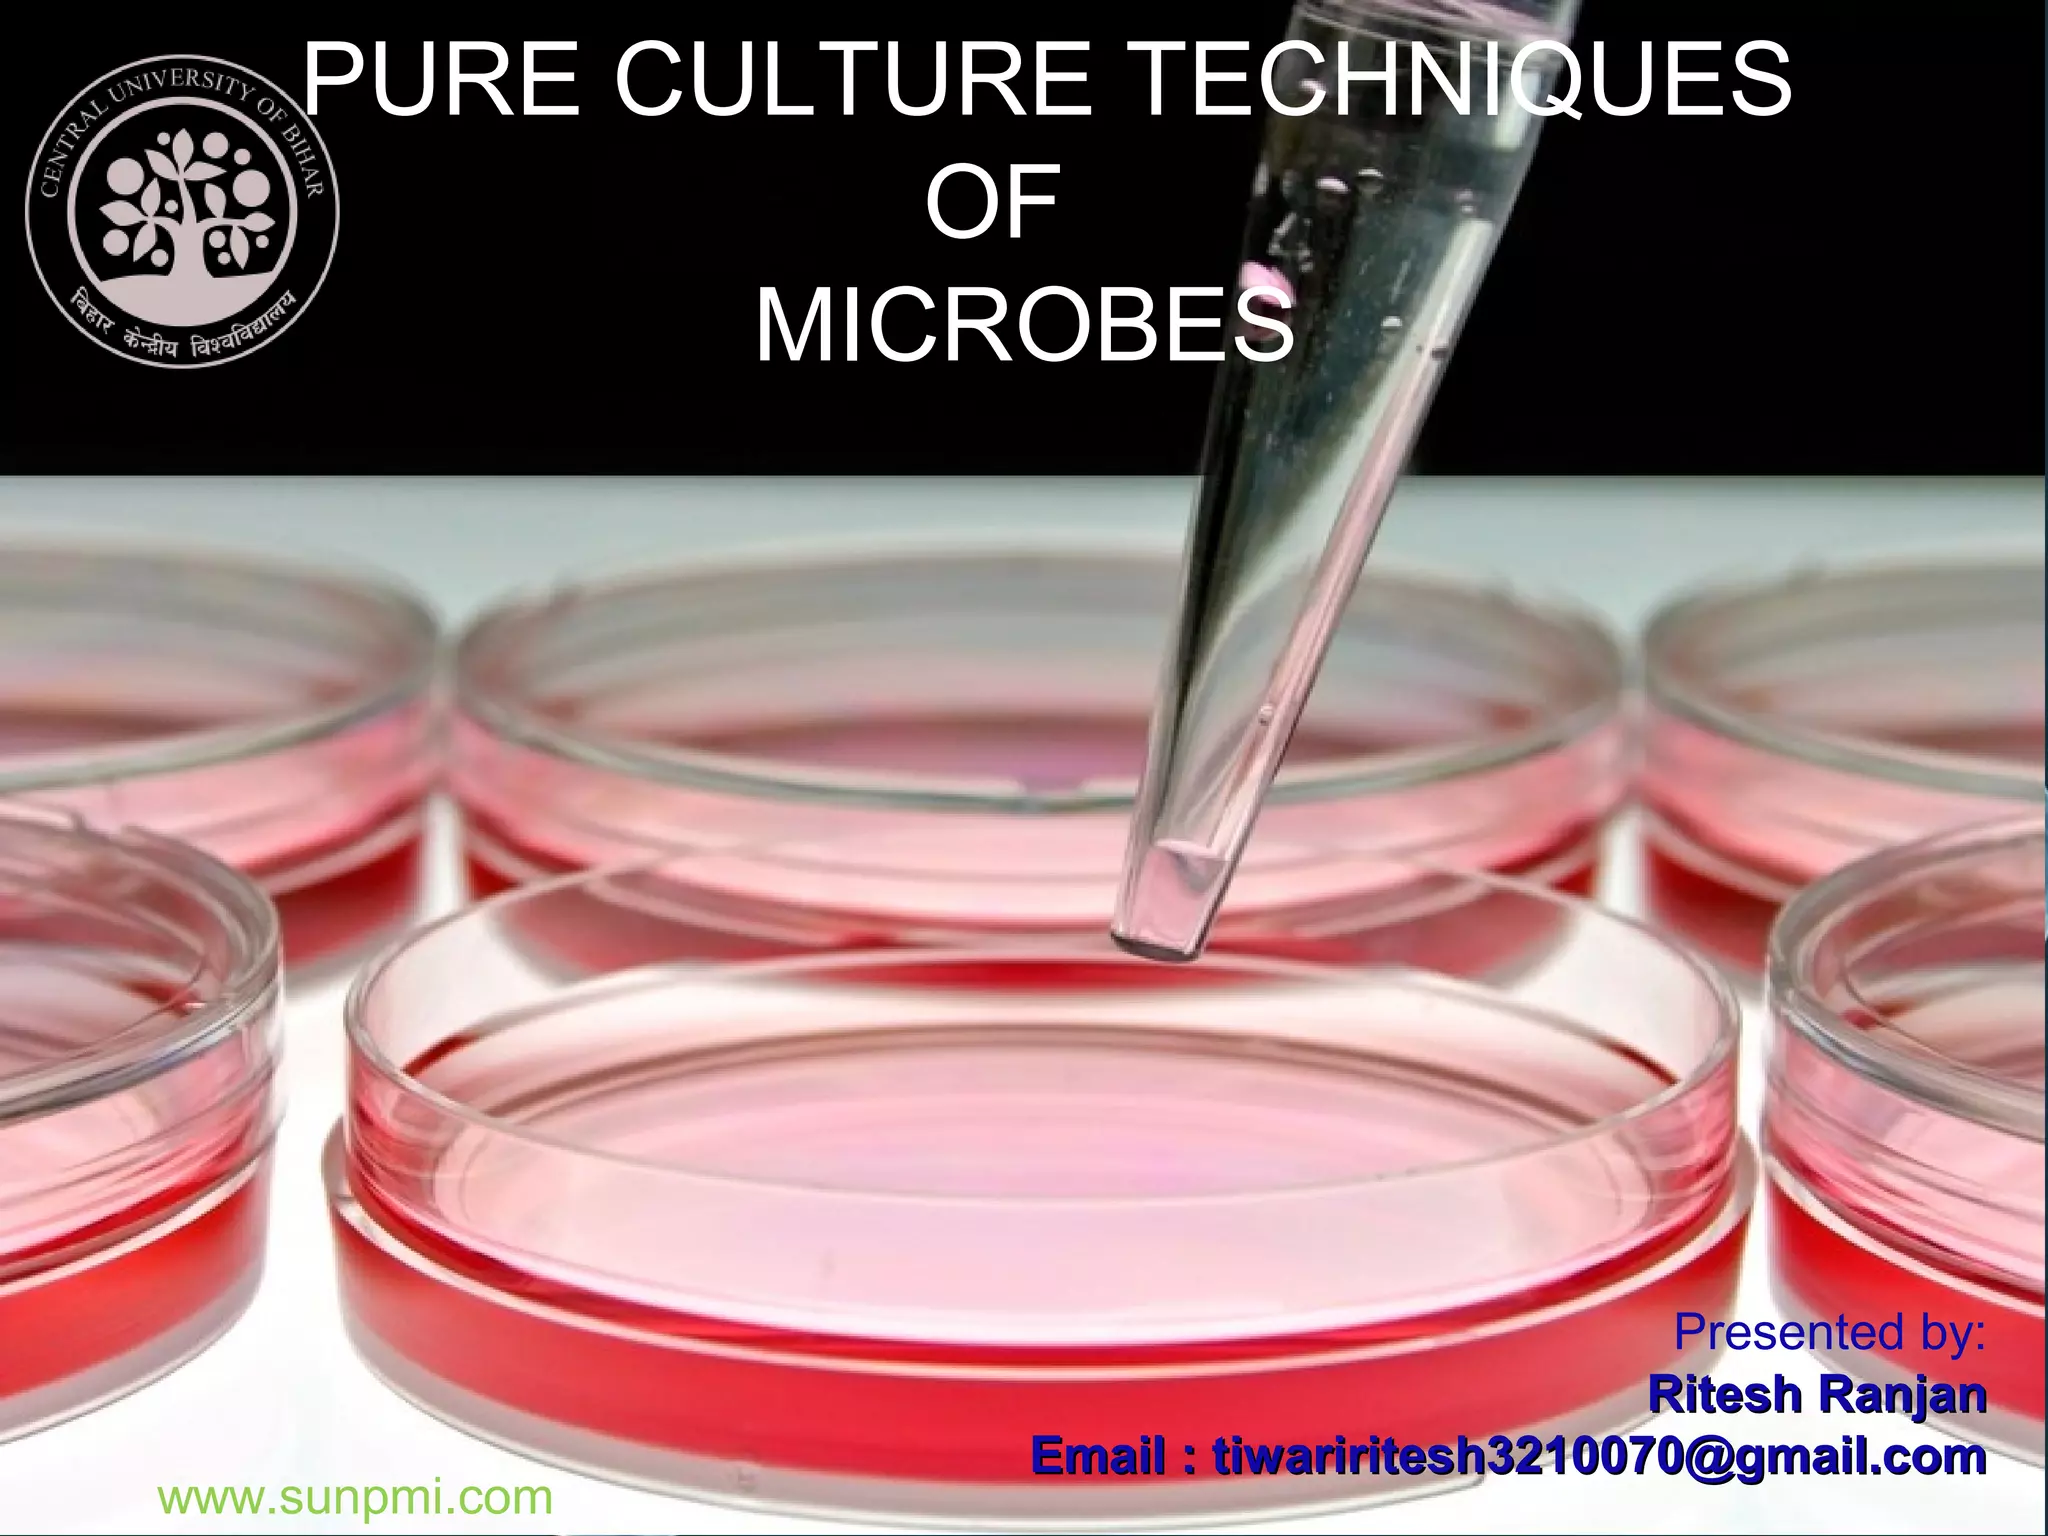

Pure cultures are important in microbiology because they allow for the accurate study and identification of microorganisms. There are three main techniques involved in obtaining a pure culture: sterilization of materials to prevent contamination, aseptic transfer of microbes to growth media, and isolating single cells or their progeny. Some common isolation methods are streak plating, spread plating, and serial dilution plating. Once a pure culture is obtained, its purity can be demonstrated by the uniform appearance of colonies and identical growth characteristics of isolated colonies. Pure cultures must then be maintained through refrigeration, paraffin coating, cryopreservation, or lyophilization to preserve them for long-term storage and future use.